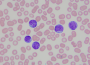
AML WG_100x1 AML WG_100x1

Home » February 19th, 2022
Entries posted on “February, 2022”

Show Name: Lakeland Winter Haven Kennel Club Location: Lakeland, FL Show Date: Saturday, February 19, 2022 Total Entry: 1583 Best In Show Judge: Harry H. (Butch) Schulman Show Photographer(s): Don Meyer • Email: BillMeyerPhoto@gmail.com Dog Reg: GCH Brighton Hightide Valkyrie [Bitch] Breed: Poodle (Standard) Handler: Christian Manelopoulos Owner: Missy Galloway, Karen LeFrak & Anita Carter Breeder: […]
February 19th, 2022 | Posted in All Breed Show Results | Read More »

ARLINGTON, Va., Feb. 17, 2022 /PRNewswire/ — Meals on Wheels America, the national leadership organization supporting community-based programs across the U.S. dedicated to addressing senior isolation and hunger, announced it has received a $500,000 grant from PetSmart Charities®, the leading funder of animal welfare in North America.
February 19th, 2022 | Posted in Current Articles,Featured | Read More »

Those who judge know that faults and virtues vary in their degree of severity and in the frequency of their occurrence from dog to dog and from breed to breed. Because virtues and faults occur in all breeds the challenge is to recognize the average dog from the better and the best ones.
February 19th, 2022 | Posted in Current Articles,Dog Show History,Featured | Read More »

Losing a dog to cancer is always devastating, but losing one to acute myeloid leukemia (AML) is an especially heart-wrenching experience because it happens so fast.
February 19th, 2022 | Posted in Current Articles,Featured | Read More »

Show Name: Sun Maid Kennel Club of Fresno, Inc. Location: Fresno, CA Show Date: Friday, February 18, 2022 Total Entry: 1405 Best in Show Judge: Mr. Ronald V. Horn Show Photographer(s): Victoria & Warren Cook – MyDogPhoto • Website: mydogphoto.com Dog Reg: GCH Vin-Melcas The Jaywalker [Bitch] Breed: Norwegian Elkhound Handler: Pat Trotter Owner: Patricia V Trotter & […]
February 18th, 2022 | Posted in All Breed Show Results | Read More »

Show Name: West Texas Kennel Club Location: Midland, TX Show Date: Friday, February 18, 2022 Total Entry: 1045 Best In Show Judge: Mrs. Judith A. Brown Show Photographer(s): Malinda Julien • Website: k9malinda.zenfolio.com Dog Reg: GCHG Southports Ares God Of War [Dog] Breed: Mastiff Handler: Randy McAteer Owner: C & A Sanchez, D Hall & […]
February 18th, 2022 | Posted in All Breed Show Results | Read More »

Show Name: Lakeland Winter Haven Kennel Club Location: Lakeland, FL Show Date: Friday, February 18, 2022 Total Entry: 1387 Best In Show Judge: Mrs. Patricia Lanctot Show Photographer(s): Don Meyer • Email: BillMeyerPhoto@gmail.com Dog Reg: GCHG Kan Trace Very Cheeky Chic [Bitch] Breed: Lagotti Handler: Phil Booth Owner: J Armstrong, V Malzoni Jr., S Zdunic Sinkovic […]
February 18th, 2022 | Posted in All Breed Show Results | Read More »

Dennis McCoy gives his thoughts on the recent email sent to AKC from judging operations…
February 18th, 2022 | Posted in Videos | Read More »

Traditionally, many retriever owners who weren’t interested in breeding their dogs opted to have them spayed or neutered.
February 18th, 2022 | Posted in Current Articles,Featured | Read More »

If the past two years were a phenomenon, they’d be a natural disaster. Unpredicted, unpredictable, and unsettling, and it’s unknown what “normal” will look like or when it’ll finally show up.
February 18th, 2022 | Posted in Current Articles,Featured | Read More »